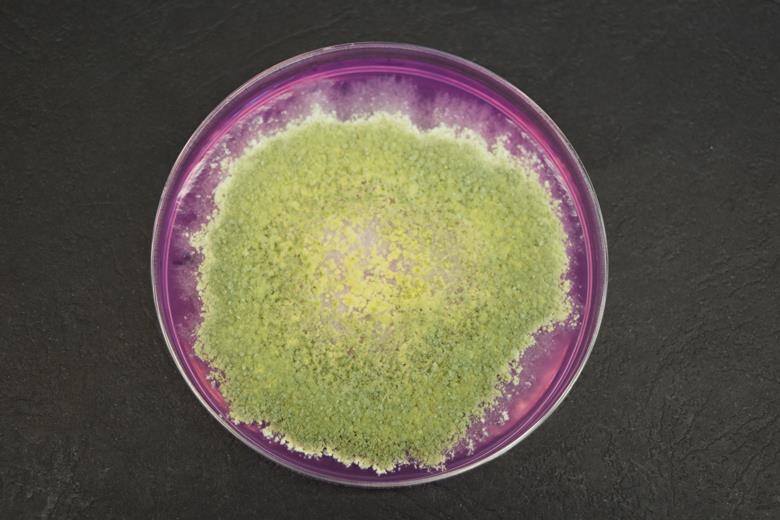
6660_eft17t2_7.4tga5mh_41470.jpg

Fungus shows promise to battle plant pathogens in wheat crops
An endophytic fungus shows promise in fighting plant pathogens in wheat crops, boosting productivity and improving sustainability by providing an alternative to
A moderately disease susceptible bread wheat was grown at a low rainfall, minimum tillage, stubble-retained site, previously cropped to wheat for six consecutive years and shown to be highly conducive to both diseases.
Diagnostic microbiological and species-specific qPCR approaches determined the rhizosphere dynamics of strain A5MH and the target pathogens at tillering, grain harvest and in postharvest stubble over another two consecutive cropping seasons.
Actively colonizing
The study demonstrated that the inoculant actively colonized the wheat rhizosphere throughout both low rainfall growing seasons, suppressed pathogen abundance in wheat roots and persisted postharvest in roots and soil of standing stubble over summer for at least 293 days post inoculation. Inoculant strain A5MH consistently increased crop emergence and plant biomass at tillering and whilst not statistically significant, the inoculant also enhanced grain yields by 12% to 20% in both trial years.
While Pythium root rot caused by G. irregulare is generally considered to be more active at seedling and vegetative growth stages in cooler and wetter soils, this study observed high frequencies of root infection by this pathogen in a low rainfall cropping system and it negatively impacted plant performance throughout the year.
Novel finding
“The active root colonisation and persistence of a Trichoderma inoculant in wheat stubble, in a warm, low rainfall Mediterranean climate is a novel finding and highlights the endophytic nature of the strain,” Dr Stummer said.
“Despite strain A5MH not being detected in soil prior to inoculation in either year, reinoculation to the same plots in the second consecutive year resulted in greater abundance of the strain throughout the growing season and persistence of the inoculant in soil postharvest. Greater persistence in the second year of application may be related to changes in the rhizosphere microbiome and warrants further investigation.”
The study showed that T. gamsii strain A5MH has potential to improve integrated management of Pythium-Fusarium root disease complexes in cereals.
Synthetic pesticides
“Overuse of synthetic pesticides has contributed to the widespread emergence of resistance in target pests and subsequently, reduced effectiveness and durability of pest management. Microbial suppression of crop diseases has potential to enhance the sustainability of plant production systems by reducing the reliance on synthetic pesticides,” Dr Stummer said.
“Environmental benefits that may be achieved through inoculant suppression of root diseases include reduced reliance on synthetic pesticides, improved weed management through enhanced crop establishment and minimising adverse impacts of fertilisers and pesticidesagri-chemicals on and off farm, via more efficient use of these agricultural inputs.
Environmental contamination
“Widespread pesticide use can also result in ecotoxicity, their use contaminating the environment and impacting on agri-ecosystem functions.
“Reduced effectiveness due to pesticide resistance and market demands for more sustainable products are driving novel approaches for pest control in agriculture. The increasing adoption of organic farming, concerns for soil health, agricultural sustainability and environmental safety are key factors driving growth of alternatives to chemicals in the agriculture industry.
“Globally environments are warming, and new options are needed to combat crop diseases, especially those that are exacerbated under warmer and drier climatic conditions (e.g. Fusarium crown rot).”
Higher rainfall regions
Further trials are needed to determine if strain A5MH-and the induced pathogen suppression translates to yield improvements in higher rainfall regions where non-cereal rotations can reduce crown rot inoculum,” Dr Stummer said.
“Future research will assess the impacts of consecutive A5MH treatments on the rhizosphere dynamics of indigenous fungal and oomycete communities, and interactions associated with the enhanced inoculant abundance and disease suppression reported in the present study.
“Modulation of defence-related gene expression in wheat by strain A5MH may be associated with suppression of G. irregulare and F. pseudograminearum and requires further investigation.”
The study was led by Dr Paul Harvey. The work was primarily supported by CSIRO and the Australian Department of Agriculture, Water and the Environment (DAWE).
‘Wheat rhizosphere dynamics of Trichoderma gamsii A5MH and suppression of a Pythium root rot-Fusarium crown rot disease complex over two consecutive cropping seasons.’ is published in Journal of Applied Microbiology.
